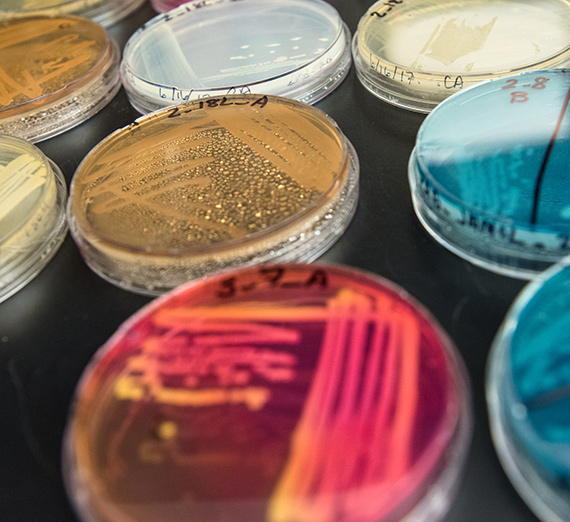

About
Gonzaga’s Jesuit, Catholic, Humanistic education will challenge and inspire you.

When we educate future doctors and nurses, psychologists and pharmacists, Gonzaga ensures that those in need receive the compassionate care they deserve. That’s part of our commitment to service—and to healing the world we all share.

As the demand for quality, innovative healthcare rises, Gonzaga is responding. We’re forming exceptional partnerships, creating interdisciplinary internships, and fostering a spirit of innovation in the life sciences. Whether your career aspirations take you to the surgery suite - or to the research lab - exploring the science of life requires a firm foundation.

In the Catholic, Jesuit and Humanistic traditions, your learning prepares you to work toward a more just world. You’ll cultivate an understanding of what it means to be human, to experience a well-lived life, to find your role in a more humane global community.
Your educational journey expands year by year with these principals of our Core curriculum:
You’ll also uncover the richness of interdisciplinary studies, where courses blend biology and dance, faith and science, politics and literature. All to equip you for the next part of your journey, where purpose and potential evolve.

We know there's something big in store for you. This is where you'll find it.
At Gonzaga, you'll connect your passion with a purpose.